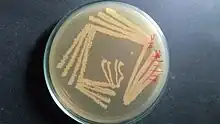

| Kytococcus sedentarius | |
|---|---|
![]() | |
| Kytococcus sedentarius culture on Zobell's Marine Agar (Himedia) plate (quadrant streak plate). | |
| Scientific classification | |
| Domain: | Bacteria |
| Phylum: | Actinomycetota |
| Class: | Actinomycetia |
| Order: | Micrococcales |
| Family: | Kytococcaceae |
| Genus: | Kytococcus |
| Species: | K. sedentarius |
| Binomial name | |
| Kytococcus sedentarius | |
| Type strain | |
| ATCC 14392[3] CCM 314 CCUG 33030 CIP 81.72 DSM 20547 IFO 15357 JCM 11482 LMG 14228 NBRC 15357 NCTC 11040 VKM B-1316 | |
| Synonyms | |
| |
Kytococcus sedentarius is a marine dwelling Gram positive bacterium in the genus Kytococcus.[1][2] It is known for the production of polyketide antibiotics as well as for its role as an opportunistic pathogen. It is strictly aerobic and can only grow when amino acids are provided.
It is found in tetrads, irregular clusters, and cubical packets of eight. It is catalase positive, oxidase positive, and exhibits strictly aerobic metabolism. Optimum growth temperature is 25-37 C. It is primarily isolated from human skin, and is one of the major causes of pitted keratolysis.[4][5] Once considered a species of the genus Micrococcus.[6]
Genome
The genome has been sequenced and contains 2,785,024 bp,[7] which is among the smallest for Actinomycetes, with a G+C content of 71.6%. This encodes 2639 protein coding genes.
References
- 1 2 Zobell CE, Upham HC. (1944). "A list of marine bacteria including descriptions of sixty new species". Bulletin Scripps Institution of Oceanography University of California (Technical Series). 5: 239–292.
- 1 2 Stackebrandt E, Koch C, Gvozdiak O, Schumann P (1995). "Taxonomic dissection of the genus Micrococcus: Kocuria gen. nov., Nesterenkonia gen. nov., Kytococcus gen. nov., Dermacoccus gen. nov., and Micrococcus Cohn 1872 gen. emend". Int J Syst Bacteriol. 45 (4): 682–692. doi:10.1099/00207713-45-4-682. PMID 7547287.
- ↑ Parte, A.C. "Kytococcus". LPSN.
- ↑ Longshaw, C. M.; Wright, J. D.; Farrell, A. M.; Holland, K. T. (2002). "Kytococcus sedentarius, the organism associated with pitted keratolysis, produces two keratin-degrading enzymes". Journal of Applied Microbiology. 93 (5): 810–816. doi:10.1046/j.1365-2672.2002.01742.x. ISSN 1364-5072. PMID 12392527.
- ↑ Makhecha, Meena; Dass, Shreya; Singh, Tishya; Gandhi, Riddhi; Yadav, Tulika; Rathod, Dipali (November 2017). "Pitted keratolysis—a study of various clinical manifestations". International Journal of Dermatology. 56 (11): 1154–1160. doi:10.1111/ijd.13744. ISSN 1365-4632. PMID 28924971. S2CID 23775733.
- ↑ "Kytococcus sedentarius". www.vumicro.com. Retrieved 2016-07-08.
- ↑ Sims, David; Brettin, Thomas; Detter, John C.; Han, Cliff; Lapidus, Alla; Copeland, Alex; Del Rio, Tijana Glavina; Nolan, Matt; Chen, Feng; Lucas, Susan; Tice, Hope; Cheng, Jan-Fang; Bruce, David; Goodwin, Lynne; Pitluck, Sam; Ovchin-Nikova, Galina; Pati, Amrita; Ivanova, Natalia; Mavrommatis, Konstantinos; Chen, Amy; Palaniappan, Krishna; d'Haeseleer, Patrik; Chain, Patrick; Bristow, Jim; Eisen, Jonathan A.; Markowitz, Victor; Hugenholtz, Philip; Schneider, Susanne; Göker, Markus; et al. (2009). "Complete genome sequence of Kytococcus sedentarius type strain (541)". Stand Genomic Sci. 1 (1): 12–20. doi:10.4056/sigs.761. PMC 3035214. PMID 21304632.
Further reading
- Gao, Min; Wang, Ke; Su, Rongguo; Li, Xuzhao; Lu, Wei (Jul 2014). "Antifouling potential of bacteria isolated from a marine biofilm". Journal of Ocean University of China. 13 (5): 799–804. Bibcode:2014JOUC...13..799G. doi:10.1007/s11802-014-2469-9. S2CID 88398988.
External links